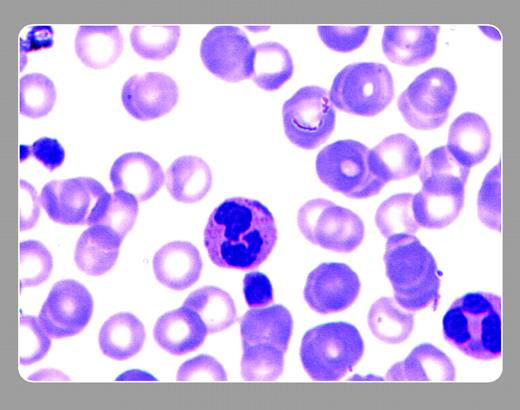
Figure 1. A 45-year-old African American woman had moderately excessive bleeding within an hour after an abdominal hysterectomy. Her platelet count was 54 × 109/L, and the preoperative platelet count that was not evaluated was 85 × 109/L. Her brother had a low platelet count years prior, diagnosed as “idiopathic thrombocytopenic purpura” and treated by splenectomy. Her peripheral smear showed large platelets and Döhle bodies within many of the polymorphonuclear leukocytes. A diagnosis of May-Hegglin anomaly was made. Months later, the mother visited the emergency room with an upper respiratory infection and had a complete blood count showing mild thrombocytopenia. Her peripheral smear also had large platelets and Döhle bodies. . / May-Hegglin is an autosomal dominant disorder that was originally described by May (1909) and later by Hegglin (1945). Other instances of thrombocytopenia with large platelets, many of which also include Döhle bodies were reported later, such as Sebastian syndrome, Fechtner syndrome, and Epstein syndrome. All have a common genetic mutation (MYH9) that encodes for nonmuscle myosin heavy chain IIA that is expressed in platelets, renal cells, granulocytes and the cochlea. . / Clinically, thrombocytopenia in May-Heggelin does not often cause bleeding except with surgery or trauma. Recognition of the familial history and the peripheral blood smear eliminates the need for further laboratory testing or a bone marrow examination. . / Neil Abramson, Baptist Cancer Institute

A 45-year-old African American woman had moderately excessive bleeding within an hour after an abdominal hysterectomy. Her platelet count was 54 × 109/L, and the preoperative platelet count that was not evaluated was 85 × 109/L. Her brother had a low platelet count years prior, diagnosed as “idiopathic thrombocytopenic purpura” and treated by splenectomy. Her peripheral smear showed large platelets and Döhle bodies within many of the polymorphonuclear leukocytes. A diagnosis of May-Hegglin anomaly was made. Months later, the mother visited the emergency room with an upper respiratory infection and had a complete blood count showing mild thrombocytopenia. Her peripheral smear also had large platelets and Döhle bodies.
May-Hegglin is an autosomal dominant disorder that was originally described by May (1909) and later by Hegglin (1945). Other instances of thrombocytopenia with large platelets, many of which also include Döhle bodies were reported later, such as Sebastian syndrome, Fechtner syndrome, and Epstein syndrome. All have a common genetic mutation (MYH9) that encodes for nonmuscle myosin heavy chain IIA that is expressed in platelets, renal cells, granulocytes and the cochlea.
Clinically, thrombocytopenia in May-Heggelin does not often cause bleeding except with surgery or trauma. Recognition of the familial history and the peripheral blood smear eliminates the need for further laboratory testing or a bone marrow examination.
Neil Abramson, Baptist Cancer Institute
A 45-year-old African American woman had moderately excessive bleeding within an hour after an abdominal hysterectomy. Her platelet count was 54 × 109/L, and the preoperative platelet count that was not evaluated was 85 × 109/L. Her brother had a low platelet count years prior, diagnosed as “idiopathic thrombocytopenic purpura” and treated by splenectomy. Her peripheral smear showed large platelets and Döhle bodies within many of the polymorphonuclear leukocytes. A diagnosis of May-Hegglin anomaly was made. Months later, the mother visited the emergency room with an upper respiratory infection and had a complete blood count showing mild thrombocytopenia. Her peripheral smear also had large platelets and Döhle bodies.
May-Hegglin is an autosomal dominant disorder that was originally described by May (1909) and later by Hegglin (1945). Other instances of thrombocytopenia with large platelets, many of which also include Döhle bodies were reported later, such as Sebastian syndrome, Fechtner syndrome, and Epstein syndrome. All have a common genetic mutation (MYH9) that encodes for nonmuscle myosin heavy chain IIA that is expressed in platelets, renal cells, granulocytes and the cochlea.
Clinically, thrombocytopenia in May-Heggelin does not often cause bleeding except with surgery or trauma. Recognition of the familial history and the peripheral blood smear eliminates the need for further laboratory testing or a bone marrow examination.
Neil Abramson, Baptist Cancer Institute
Many Blood Work images are provided by the ASH IMAGE BANK, a reference and teaching tool that is continually updated with new atlas images and images of case studies. For more information or to contribute to the Image Bank, visit www.ashimagebank.org.
This feature is available to Subscribers Only
Sign In or Create an Account Close Modal